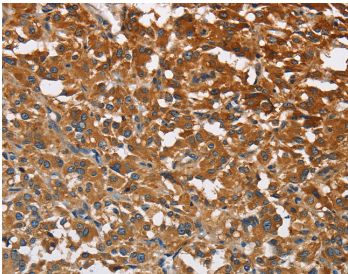

工作时间 :
周一~~周五
9:00 -18:00
在非工作时间,您可以通过邮件订购产品,订购时请写明详细联系方式,谢谢支持!
销售:18321282235
技术:021-60514606
传真:021-37680378
顾经理微信 扫一扫,关注我们
ATP1B2 Polyclonal Antibody
AMOG
货号:YBAP15075 |
|
![]() |
|
规格: 50ul/100ul/200ul |
|
价格: 980/1280/1890 |
|
| Immunogen: | Recombinant protein of human ATP1B2 | ||
Synonym: |
AMOG | ||
| Calculated MW: | |||
| Observed MW: | |||
Source: |
Rabbit | ||
Isotype: |
IgG | ||
Application: |
ELISA IHC | ||
Purify: |
Affinity purification | ||
Concentration: |
1.4mg/ml | ||
Storage Buffer: |
PBS with 0.05% sodium azide, 50% glycerol, pH7.3 | ||
Storage: |
Store at -20℃. Avoid freeze / thaw cycles. |
||
| Immunohistochemistry of Human colon cancer using ATP1B2 Polyclonal Antibody at dilution of 1:30 |
Protocols: |
Buffer-Formulation WB-Guide IHC-Guide IP-Guide IF-Guide |
||
Background: |
The protein encoded by this gene belongs to the family of Na+/K+ and H+/K+ ATPases beta chain proteins, and to the subfamily of Na+/K+ -ATPases. Na+/K+ -ATPase is an integral membrane protein responsible for establishing and maintaining the electrochemical gradients of Na and K ions across the plasma membrane. These gradients are essential for osmoregulation, for sodium-coupled transport of a variety of organic and inorganic molecules, and for electrical excitability of nerve and muscle. This enzyme is composed of two subunits, a large catalytic subunit (alpha) and a smaller glycoprotein subunit (beta).
|
||
部门 |
姓名 | 手机 | |||
| 销售部 | 顾先生 | 1916510334@qq.com | 18321282235 | 1916510334 | |
| 技术部 | 技术支持 | 1781364813@qq.com | 13816899465 | 1781364813 |
全国免费电话:18321282235
销售: 18321282235
86-21-60514606
技术: 13816899465
传真: 021-37680378
The latest products